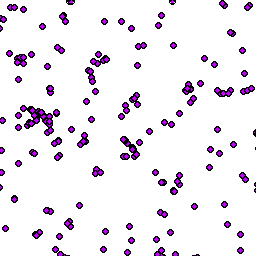

[unknown data provider] |
|
Adresni_mista_Adresni_mista
http://arcgis.kr-karlovarsky.cz/arcgis/services/Adresni_mista/Adresni_mista/MapServer/WMSServer
| Service health Now: |
|---|
- Interface
- Web Service, OGC Web Map Service 1.3.0
- Keywords
- Fees
- unknown
- Access constraints
- unknown
- Supported languages
- No INSPIRE Extended Capabilities (including service language support) given. See INSPIRE Technical Guidance - View Services for more information.
- Data provider
-
unknown (unverified)
Contact information:
- Service metadata
- No INSPIRE Extended Capabilities (including service metadata) given. See INSPIRE Technical Guidance - View Services for more information.